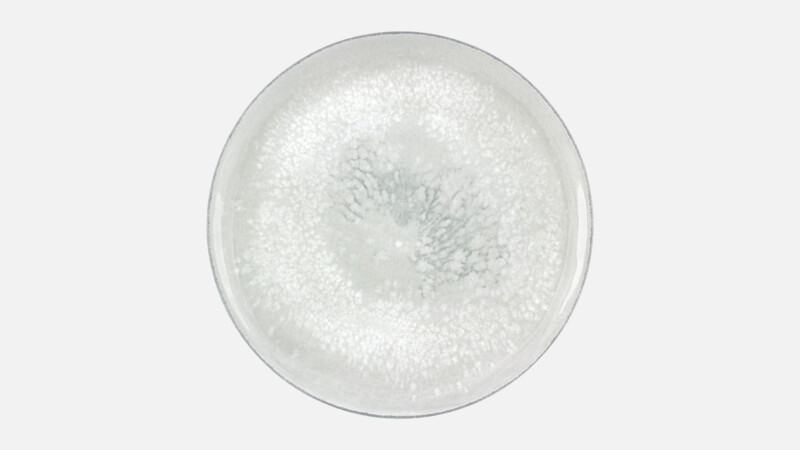
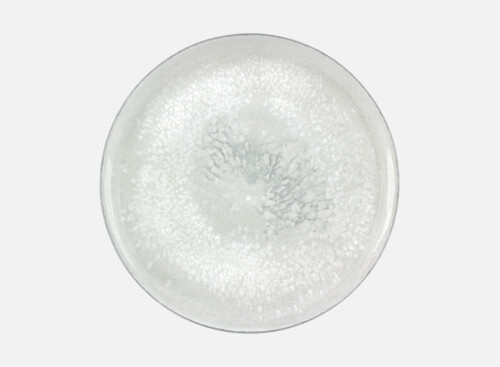
Teller flach rund coup 26cm

SMART - Teller flach rund coup
EAN: 4025068874765
- Artikelnummer: 6 75 1228 11 425943
- Durchmesser: 281 mm / 11.06 inch
- Höhe (1 Stück): 23 mm / 0.91 inch
- Höhe 11 Stück: 136 mm / 5.35 inch
- Gewicht: 835 g
- Verpackungseinheit: 6
- Spiegeldurchmesser: 281 mm / 11.06 inch
SMART - Teller flach rund coup - Speiseteller 28cm
Schließen sich optische Hingucker und aktuelle Hygiene-Konzepte aus? Ein klares Nein. Die neuen Smart-Dekore sind spülmaschinenfest und haben eine genauso dichte Oberfläche wie undekoriertes Geschirr. Die Kombination aus Dekor und Farbglasur zaubert Vielfalt auf den Tisch – ohne in eine Vielzahl von Artikeln zu investieren.-
Spülmaschinengeeignet
-
Mikrowellengeeignet
-
Heiße Oberflächen
-
Verletzung durch Splitter
Hersteller: BHS tabletop AG, Ludwigsmühle 1, 95100, Selb, Deutschland, info@bhs-tabletop.de